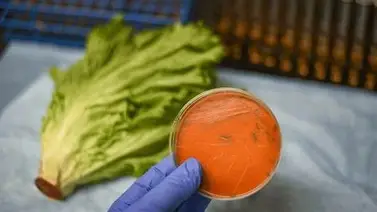
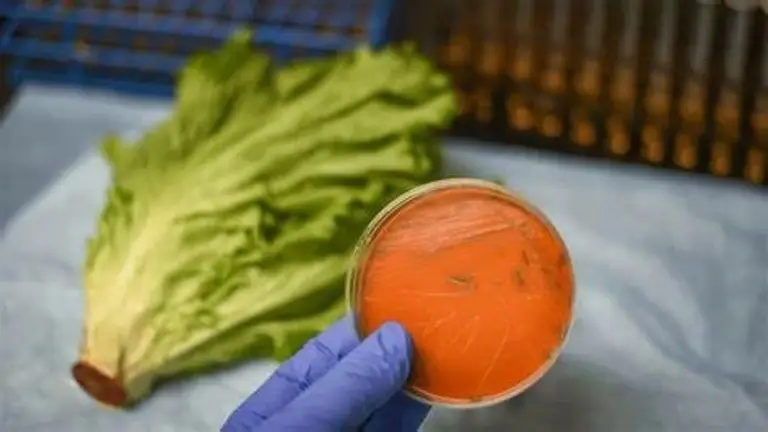

La Administración de Alimentos y Medicamentos (FDA) ha emitido una alerta tras el retiro del mercado de varios alimentos listos para consumir, vinculados a un brote de listeria que ha dejado al menos 10 personas hospitalizadas en California y Nevada. La medida se tomó como precaución para salvaguardar la salud pública.
Productos afectados
Fresh Ready Foods ha decidido retirar voluntariamente del mercado varios productos, que incluyen sándwiches, pastas y snacks, debido a la posible presencia de listeria. La FDA ha señalado que los productos retirados no requieren cocción adicional y tienen fechas de caducidad que van del 22 de abril al 19 de mayo.
Marcas en riesgo
Entre las marcas afectadas se encuentran:
• Fresh Ready Foods
• City Point Market Fresh Food to Go
• Fresh Take Crave Away
Aunque no se han reportado enfermedades específicas asociadas con estos productos vendidos entre el 18 y el 28 de abril, la decisión de retirar los alimentos se tomó como una medida preventiva.
Distribución geográfica de los productos
Los alimentos retirados fueron distribuidos en varios estados, incluyendo Arizona, California, Nevada y Washington. Estos productos se vendieron en diferentes puntos de venta, tales como hospitales, hoteles, tiendas de conveniencia, aeropuertos y aerolíneas.
Hospitalizaciones reportadas
Hasta el viernes, se habían registrado 8 hospitalizaciones en California y 2 en Nevada debido a infecciones por listeria entre diciembre de 2023 y septiembre de 2024, según los Centros para el Control y la Prevención de Enfermedades (CDC). La FDA ha indicado que más de 75 productos se vieron afectados por este brote.
Recomendaciones para los consumidores
La FDA ha instado a los consumidores a no consumir los productos retirados y a limpiar y desinfectar cualquier superficie que haya estado en contacto con ellos. La investigación sobre este brote comenzó el año pasado, pero no se identificó la fuente en ese momento. Sin embargo, la FDA reabrió la investigación el mes pasado después de detectar listeria en muestras de Fresh Ready Foods durante una inspección rutinaria. Un análisis posterior confirmó que la cepa de listeria encontrada coincidía con la que causó el brote.